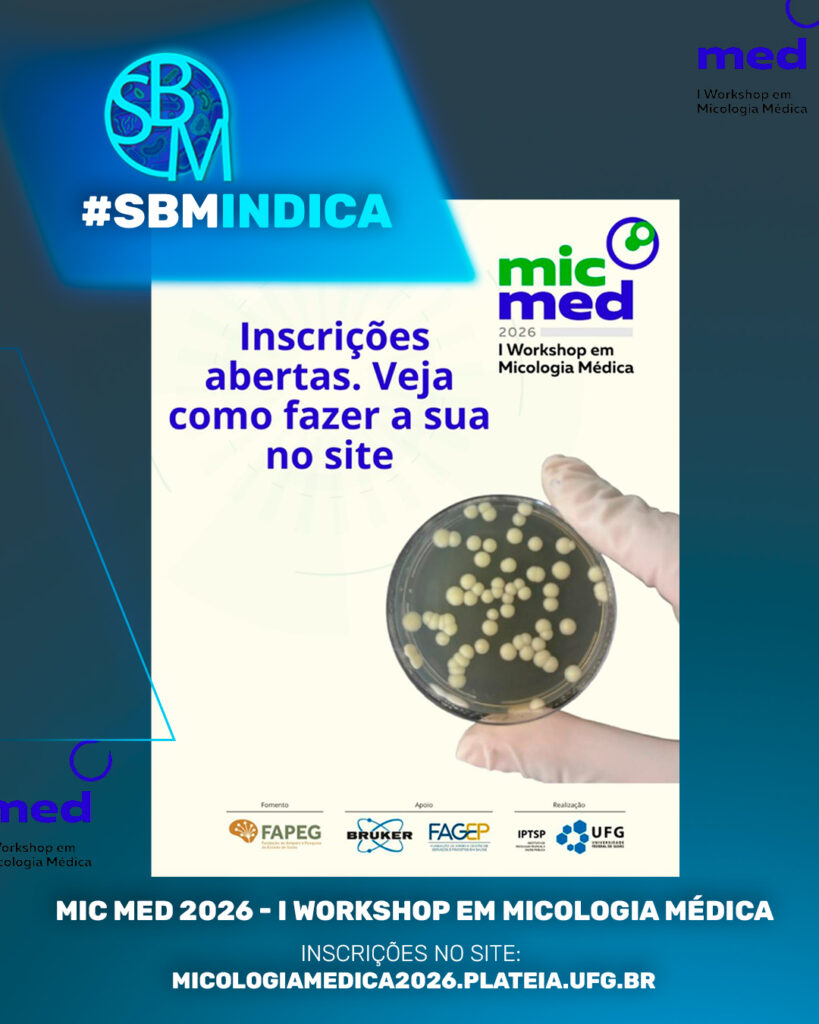
07.01-SBM-indica

O I Workshop de Micologia Médica da UFG acontecerá nos dias 27 e 28 de março de 2026.
O encontro reunirá especialistas para discutir diagnóstico, tratamento e vigilância das infecções fúngicas, além das principais micoses de relevância clínica no Brasil.
Para mais informações, acesse @micologiamed no Instagram.


